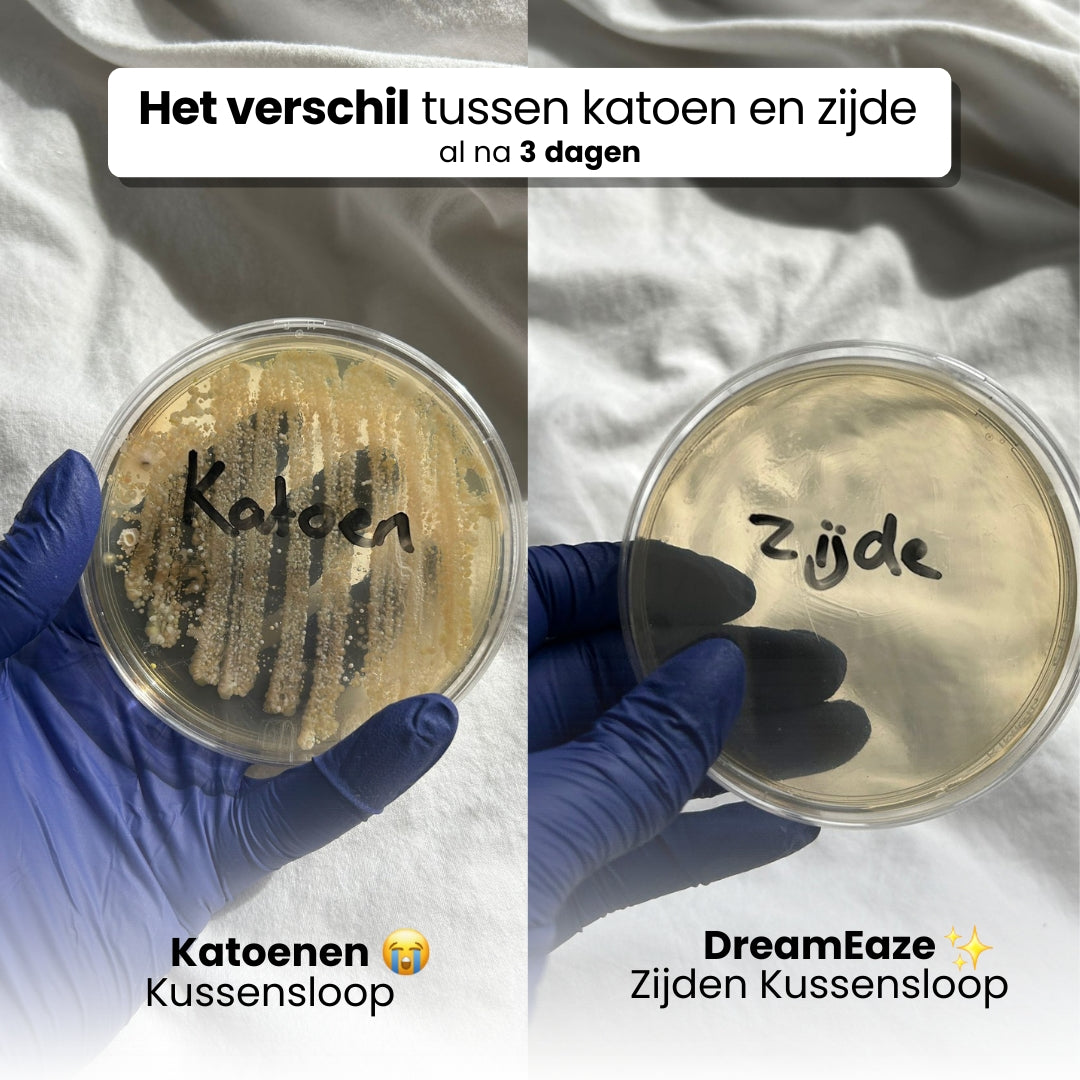

Zorg voor huid en haar terwijl je slaapt
Geniet van gezonder en zachter haar met onze zijden kussenslopen. In tegenstelling tot katoen vermindert zijde wrijving en voorkomt het klitten en haarbreuk. Dit helpt om gespleten haarpunten te voorkomen en behoudt de natuurlijke glans van je haar. Daarnaast is zijde zacht voor je huid. Het minimaliseert slaapvouwen en voorkomt dat vocht uit je huid wordt onttrokken. Zo word je elke ochtend fris en stralend wakker, terwijl je huid gehydrateerd blijft.